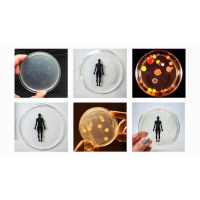
Smelfies, and other experiments in synthetic biology | Ani Liu

Synopsis
Want TED Talks on the go? Every weekday, this feed brings you our latest talks in audio format. Hear thought-provoking ideas on every subject imaginable -- from Artificial Intelligence to Zoology, and everything in between -- given by the world's leading thinkers and doers. This collection of talks, given at TED and TEDx conferences around the globe, is also available in video format.
Episodes
-
An intergalactic guide to using a defibrillator | Todd Scott
12/04/2017 Duration: 05minIf Yoda goes into cardiac arrest, will you know what to do? Artist and first-aid enthusiast Todd Scott breaks down what you need to know about using an automated external defibrillator, or AED -- in this galaxy and ones that are far, far away. Prepare to save the life of a Jedi, Chewbacca (he'll need a quick shave first) or someone else in need with some helpful pointers. Hosted on Acast. See acast.com/privacy for more information.
-
In praise of conflict | Jonathan Marks
11/04/2017 Duration: 15minConflict is bad; compromise, consensus and collaboration are good -- or so we're told. Lawyer and bioethicist Jonathan Marks challenges this conventional wisdom, showing how governments can jeopardize public health, human rights and the environment when they partner with industry. An important, timely reminder that common good and common ground are not the same thing. Hosted on Acast. See acast.com/privacy for more information.
-
How we can find ourselves in data | Giorgia Lupi
07/04/2017 Duration: 11minGiorgia Lupi uses data to tell human stories, adding nuance to numbers. In this charming talk, she shares how we can bring personality to data, visualizing even the mundane details of our daily lives and transforming the abstract and uncountable into something that can be seen, felt and directly reconnected to our lives. Hosted on Acast. See acast.com/privacy for more information.
-
Political common ground in a polarized United States | Gretchen Carlson, David Brooks
03/04/2017 Duration: 47minHow can we bridge the gap between left and right to have a wiser, more connected political conversation? Journalist Gretchen Carlson and op-ed columnist David Brooks share insights on the tensions at the heart of American politics today -- and where we can find common ground. Followed by a rousing performance of "America the Beautiful" by Vy Higginsen's Gospel Choir of Harlem. Hosted on Acast. See acast.com/privacy for more information.
-
A young poet tells the story of Darfur | Emtithal Mahmoud
31/03/2017 Duration: 10minEmtithal "Emi" Mahmoud writes poetry of resilience, confronting her experience of escaping the genocide in Darfur in verse. She shares two stirring original poems about refugees, family, joy and sorrow, asking, "Will you witness me?" Hosted on Acast. See acast.com/privacy for more information.
-
"Music for Wood and Strings" | Sō Percussion
31/03/2017 Duration: 10minSō Percussion creates adventurous compositions with new, unconventional instruments. Performing "Music for Wood and Strings" by Bryce Dessner of The National, the quartet plays custom-made dulcimer-like instruments that combine the sound of an electric guitar with the percussionist's toolkit to create a hypnotic effect. Hosted on Acast. See acast.com/privacy for more information.
-
How early life experience is written into DNA | Moshe Szyf
30/03/2017 Duration: 16minMoshe Szyf is a pioneer in the field of epigenetics, the study of how living things reprogram their genome in response to social factors like stress and lack of food. His research suggests that biochemical signals passed from mothers to offspring tell the child what kind of world they're going to live in, changing the expression of genes. "DNA isn't just a sequence of letters; it's not just a script." Szyf says. "DNA is a dynamic movie in which our experiences are being written." Hosted on Acast. See acast.com/privacy for more information.
-
What we don't know about mother's milk | Katie Hinde
28/03/2017 Duration: 10minBreast milk grows babies' bodies, fuels neurodevelopment, provides essential immunofactors and safeguards against famine and disease -- why, then, does science know more about tomatoes than mother's milk? Katie Hinde shares insights into this complex, life-giving substance and discusses the major gaps scientific research still needs to fill so we can better understand it. Hosted on Acast. See acast.com/privacy for more information.
-
3 ways to spot a bad statistic | Mona Chalabi
24/03/2017 Duration: 11minSometimes it's hard to know what statistics are worthy of trust. But we shouldn't count out stats altogether ... instead, we should learn to look behind them. In this delightful, hilarious talk, data journalist Mona Chalabi shares handy tips to help question, interpret and truly understand what the numbers are saying. Hosted on Acast. See acast.com/privacy for more information.
-
Inside America's dead shopping malls | Dan Bell
17/03/2017 Duration: 11minWhat happens when a mall falls into ruin? Filmmaker Dan Bell guides us through abandoned monoliths of merchandise, providing a surprisingly funny and lyrical commentary on consumerism, youth culture and the inspiration we can find in decay. Hosted on Acast. See acast.com/privacy for more information.
-
"Turceasca" | Silk Road Ensemble
17/03/2017 Duration: 06minGrammy-winning Silk Road Ensemble display their eclectic convergence of violin, clarinet, bass, drums and more in this energetic rendition of the traditional Roma tune, "Turceasca." Hosted on Acast. See acast.com/privacy for more information.
-
Adventures of an asteroid hunter | Carrie Nugent
14/03/2017 Duration: 06minTED Fellow Carrie Nugent is an asteroid hunter -- part of a group of scientists working to discover and catalog our oldest and most numerous cosmic neighbors. Why keep an eye out for asteroids? In this short, fact-filled talk, Nugent explains how their awesome impacts have shaped our planet, and how finding them at the right time could mean nothing less than saving life on Earth. Hosted on Acast. See acast.com/privacy for more information.
-
How I'm fighting bias in algorithms | Joy Buolamwini
09/03/2017 Duration: 08minMIT grad student Joy Buolamwini was working with facial analysis software when she noticed a problem: the software didn't detect her face -- because the people who coded the algorithm hadn't taught it to identify a broad range of skin tones and facial structures. Now she's on a mission to fight bias in machine learning, a phenomenon she calls the "coded gaze." It's an eye-opening talk about the need for accountability in coding ... as algorithms take over more and more aspects of our lives. Hosted on Acast. See acast.com/privacy for more information.
-
A scientific approach to the paranormal | Carrie Poppy
03/03/2017 Duration: 13minWhat's haunting Carrie Poppy? Is it ghosts or something worse? In this talk, the investigative journalist narrates her encounter with a spooky feeling you'll want to warn your friends about and explains why we need science to deal with paranormal activity. Hosted on Acast. See acast.com/privacy for more information.
-
"Rollercoaster" | Sara Ramirez
03/03/2017 Duration: 05minSinger, songwriter and actress Sara Ramirez is a woman of many talents. Joined by Michael Pemberton on guitar, Ramirez sings of opportunity, wisdom and the highs and lows of life in this live performance of her song, "Rollercoaster." Hosted on Acast. See acast.com/privacy for more information.
-
Smelfies, and other experiments in synthetic biology | Ani Liu
27/02/2017 Duration: 07minWhat if you could take a smell selfie, a smelfie? What if you had a lipstick that caused plants to grow where you kiss? Ani Liu explores the intersection of technology and sensory perception, and her work is wedged somewhere between science, design and art. In this swift, smart talk, she shares dreams, wonderings and experiments, asking: What happens when science fiction becomes science fact? Hosted on Acast. See acast.com/privacy for more information.
-
A robot that eats pollution | Jonathan Rossiter
22/02/2017 Duration: 14minMeet the "Row-bot," a robot that cleans up pollution and generates the electricity needed to power itself by swallowing dirty water. Roboticist Jonathan Rossiter explains how this special swimming machine, which uses a microbial fuel cell to neutralize algal blooms and oil slicks, could be a precursor to biodegradable, autonomous pollution-fighting robots. Hosted on Acast. See acast.com/privacy for more information.
-
An electrifying acoustic guitar performance | Rodrigo y Gabriela
14/02/2017 Duration: 04minGuitar duo Rodrigo y Gabriela combine furiously fast riffs and dazzling rhythms to create a style that draws on both flamenco guitar and heavy metal in this live performance of their song, "The Soundmaker." Hosted on Acast. See acast.com/privacy for more information.
-
New nanotech to detect cancer early | Joshua Smith
08/02/2017 Duration: 12minWhat if every home had an early-warning cancer detection system? Researcher Joshua Smith is developing a nanobiotechnology "cancer alarm" that scans for traces of disease in the form of special biomarkers called exosomes. In this forward-thinking talk, he shares his dream for how we might revolutionize cancer detection and, ultimately, save lives. Hosted on Acast. See acast.com/privacy for more information.
-
The incredible inventions of intuitive AI | Maurice Conti
06/02/2017 Duration: 15minWhat do you get when you give a design tool a digital nervous system? Computers that improve our ability to think and imagine, and robotic systems that come up with (and build) radical new designs for bridges, cars, drones and much more -- all by themselves. Take a tour of the Augmented Age with futurist Maurice Conti and preview a time when robots and humans will work side-by-side to accomplish things neither could do alone. Hosted on Acast. See acast.com/privacy for more information.